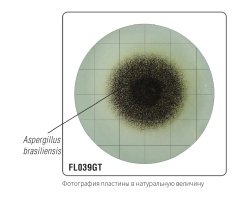
Среда Сабуро с декстрозой и нейтрализаторами (твин, лецитин, гистидин, тиосульфат) для гигиенического мониторинга (γ-облученная, в тройной упаковке) FL0039GT

Готовые к использованию пластины HiTouch™ FlexiPlate™ для контроля Coliforms, Staphylococci, Pseudomonas, Salmonella, молочнокислых бактерий, дрожжей и плесеней
Что такое FlexiPlateТМ?
HiTouchТМ FlexiPlateTM представляют собой готовые к использованию питательные среды, поставляемые в виде гибких одноразовых пластин диаметром 55 мм. На пластины нанесена сетка для облегчения подсчета колоний. Пластины обработаны гамма-облучением. Среду заполняют в стерильных условиях, каждую пластину упаковывают в предварительно стерилизованный полиэтиленовый пакет. Уникальная конфигурация гибкой пластины обеспечивает плотный контакт даже с неровными поверхностями. Пластины можно использовать не только для общего подсчета микроорганизмов, но и для селективного роста и дифференциации отдельных групп. Формулы сред FlexiPlateTM оптимально подходят для выращивания микроорганизмов окружающей среды, а сетка позволяет легко считывать количество колоний на 1 см2 пластины.
Пластины HiTouch™ FlexiPlate™ от компании HiMedia специально разработаны для проведения микробиологического контроля в сфере пищевой, фармацевтической, косметической, молочной промышленности, в больницах, на водопроводных станциях, для проведения климатических испытаний и т. д.
Пластины могут быть использованы в качестве:
1. Контактных пластин
2. Культуральных чашек
3. Пластин для работы с разбавленными пробами
4. Пластин для работы с образцами смывов
5. Пластины для контроля воздуха методом седиментации
HiTouchТМ FlexiPlateTM представляют собой готовые к использованию питательные среды, поставляемые в виде гибких одноразовых пластин диаметром 55 мм. На пластины нанесена сетка для облегчения подсчета колоний. Пластины обработаны гамма-облучением. Среду заполняют в стерильных условиях, каждую пластину упаковывают в предварительно стерилизованный полиэтиленовый пакет. Уникальная конфигурация гибкой пластины обеспечивает плотный контакт даже с неровными поверхностями. Пластины можно использовать не только для общего подсчета микроорганизмов, но и для селективного роста и дифференциации отдельных групп. Формулы сред FlexiPlateTM оптимально подходят для выращивания микроорганизмов окружающей среды, а сетка позволяет легко считывать количество колоний на 1 см2 пластины.
Пластины HiTouch™ FlexiPlate™ от компании HiMedia специально разработаны для проведения микробиологического контроля в сфере пищевой, фармацевтической, косметической, молочной промышленности, в больницах, на водопроводных станциях, для проведения климатических испытаний и т. д.
Пластины могут быть использованы в качестве:
1. Контактных пластин
2. Культуральных чашек
3. Пластин для работы с разбавленными пробами
4. Пластин для работы с образцами смывов
5. Пластины для контроля воздуха методом седиментации
|
Наши специалисты ответят на любой интересующий вопрос
|
Задать вопрос
|
Документация
|
Быстрый просмотр
|
Артикул: FL001
HiTouch™ Aerobic Count FlexiPlate™ for enumeration of aerobic microorganisms |
Запросить стоимость
|
|
Быстрый просмотр
|
Артикул: FL006
HiTouch™ Yeast and Mould Count FlexiPlate™ for enumeration of yeast & mould (fungal) population |
Запросить стоимость
|
|
Быстрый просмотр
|
Артикул: FL005
HiTouch™ Rapid Coliform Count FlexiPlate™ for enumeration of coliform bacteria |
Запросить стоимость
|
|
Быстрый просмотр
|
Артикул: FL016
HiTouch™ FlexiPlate™ - Bacillus Counts for enumeration of Bacillus species |
Запросить стоимость
|
|
Быстрый просмотр
|
Артикул: FL035GT
HiTouch™ SCDA w/ Polysorbate 80 & Lecithin Flexi Plate™ (γ-irradiated) (Triple Pack) |
Запросить стоимость
|
|
Быстрый просмотр
|
Артикул: FL0039GT
HiTouch™ Sabouraud Dextrose Agar w/ LTHTh Flexi Plate™, (γ-irradiated) (Triple Pack) |
Запросить стоимость
|
|
Быстрый просмотр
|
Артикул: FL014
HiTouch™ FlexiPlate™ - CT for enumeration of Pseudomonas aeruginosa |
Запросить стоимость
|